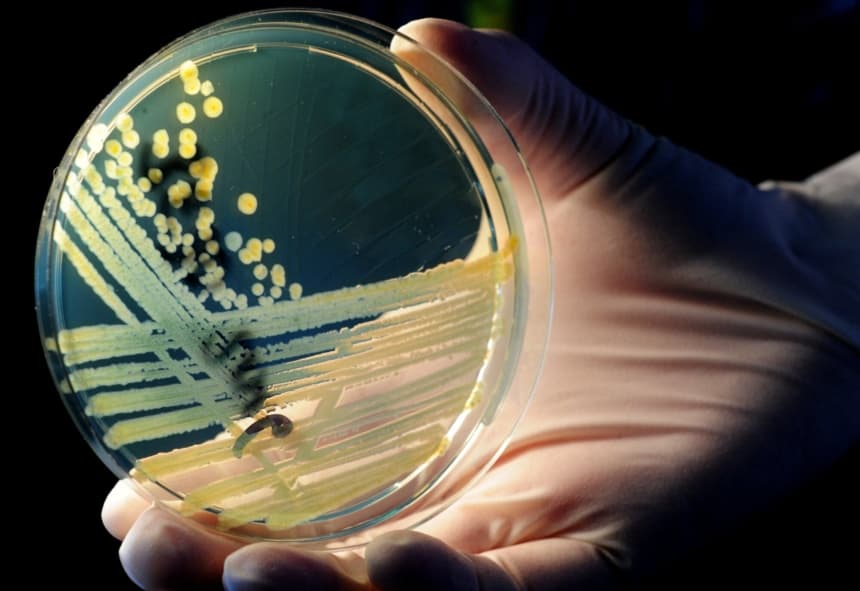
Un trabajador de laboratorio sostiene una placa de Petri con colonias de E. coli enterohemorrágica (EHEC) en un medio de cultivo en el departamento de salud pública de Baja Sajonia en Hannover, norte de Alemania, el 23 de mayo de 2011. (JULIAN STRATENSCHULTE,-/DPA/AFP via Getty Images)

Los ciudadanos etíopes residentes en Estados Unidos ya no gozarán del Estatus de Protección Temporal (TPS), tras una decisión de la secretaria de Seguridad Nacional, Kristi Noem, que se produce en medio de los continuos esfuerzos de la administración Trump por reforzar la aplicación de las leyes migratorias y frenar las protecciones temporales que, según las autoridades, pueden fomentar la inmigración ilegal.
El Departamento de Seguridad Nacional (DHS) anunció el 12 de diciembre que Noem cancelará la designación de Etiopía al TPS después de que una revisión de las condiciones del país determinara que ya no se cumplían los requisitos legales para la protección continua.
El TPS es un programa humanitario que permite a los ciudadanos de países designados que atraviesan conflictos armados, desastres naturales u otras condiciones extraordinarias permanecer temporalmente en Estados Unidos y obtener autorización de trabajo.
El gobierno de Biden amplió el TPS para cubrir a cientos de miles de migrantes de Ucrania, Afganistán, Venezuela, Haití y otros países, mientras que el gobierno de Trump ha procedido a revisar las protecciones y revertir algunas de ellas, alegando que el sistema ha sido abusado y explotado por inmigrantes indocumentados.
Fecha límite de salida, advertencia de cumplimiento
Según la decisión, los ciudadanos etíopes que no tengan otra base legal para permanecer en Estados Unidos tendrán un período de transición de 60 días para salir voluntariamente. El DHS indicó que, después del 13 de febrero de 2026, los ciudadanos etíopes sin estatus legal podrían ser arrestados y deportados. El departamento animó a las personas afectadas a usar la aplicación móvil CBP Home de la Oficina de Aduanas y Protección Fronteriza de EE. UU. para reportar su salida. El DHS indicó que la opción de auto-deportación incluye un boleto de avión gratuito, una bonificación de salida de 1000 dólares y la posibilidad de buscar vías de inmigración legal en el futuro."Si un extranjero obliga al DHS a arrestarlo y expulsarlo, es posible que nunca se le permita regresar a Estados Unidos", dijo el departamento.
En esta ilustración fotográfica, un teléfono muestra la aplicación CBP Home el 5 de mayo de 2025. (Oleksii Pydsosonnii/The Epoch Times).Parte de una reversión más amplia del TPS
La cancelación de la designación de Etiopía al TPS es la última de una serie de medidas de la administración Trump para reducir las protecciones migratorias temporales que se expandieron significativamente durante la administración Biden.En los últimos meses, el DHS anunció el fin del TPS para los nacionales de Haití, Birmania, Sudán del Sur, Siria y Venezuela, alegando que las condiciones en los respectivos países ya no justifican las protecciones especiales y, en algunos casos, argumentando que el programa se ha extendido excesivamente y fueron objeto de abuso.
"Estamos devolviendo la integridad al sistema de TPS, que fue abusado y explotado por inmigrantes indocumentados durante décadas", declaró una portavoz del DHS en un comunicado el 20 de febrero, anunciando que los nacionales de Haití ya no serían elegibles para dichas protecciones. El presidente Trump y la secretaria Noem están devolviendo el TPS a su estatus original: temporal.
Al revocar las protecciones temporales para los haitianos, el DHS afirmó que la medida formaba parte de la promesa de Trump de rescindir las políticas que atraían la inmigración ilegal y eran incompatibles con la ley.
Los intentos de revocar el TPS para algunos países han sido impugnados en cortes federales. Los jueces impidieron temporalmente que la administración cancele el TPS para ciertos grupos, como sirios y haitianos, al considerar que el DHS podría no haber seguido los procedimientos requeridos ni haber revisado adecuadamente las condiciones del país. En cambio, la Corte Suprema de Estados Unidos autorizó en octubre a la administración a revocar el TPS para cientos de miles de venezolanos.
"El presidente Trump está restaurando el sistema de inmigración estadounidense para que realmente beneficie a los ciudadanos estadounidenses, y la victoria de hoy en la Corte Suprema es una victoria para el pueblo estadounidense y el sentido común", declaró la subsecretaria del DHS, Tricia McLaughlin, en un comunicado el 3 de octubre.
Las revocaciones del TPS se producen en medio de medidas más amplias de control migratorio durante el segundo mandato de Trump. El DHS informó esta semana que más de 2.5 millones de inmigrantes indocumentados abandonaron Estados Unidos desde enero, incluyendo alrededor de 1.9 millones de inmigrantes indocumentados que se auto-deportaron voluntariamente y más de 600,000 que fueron deportados.